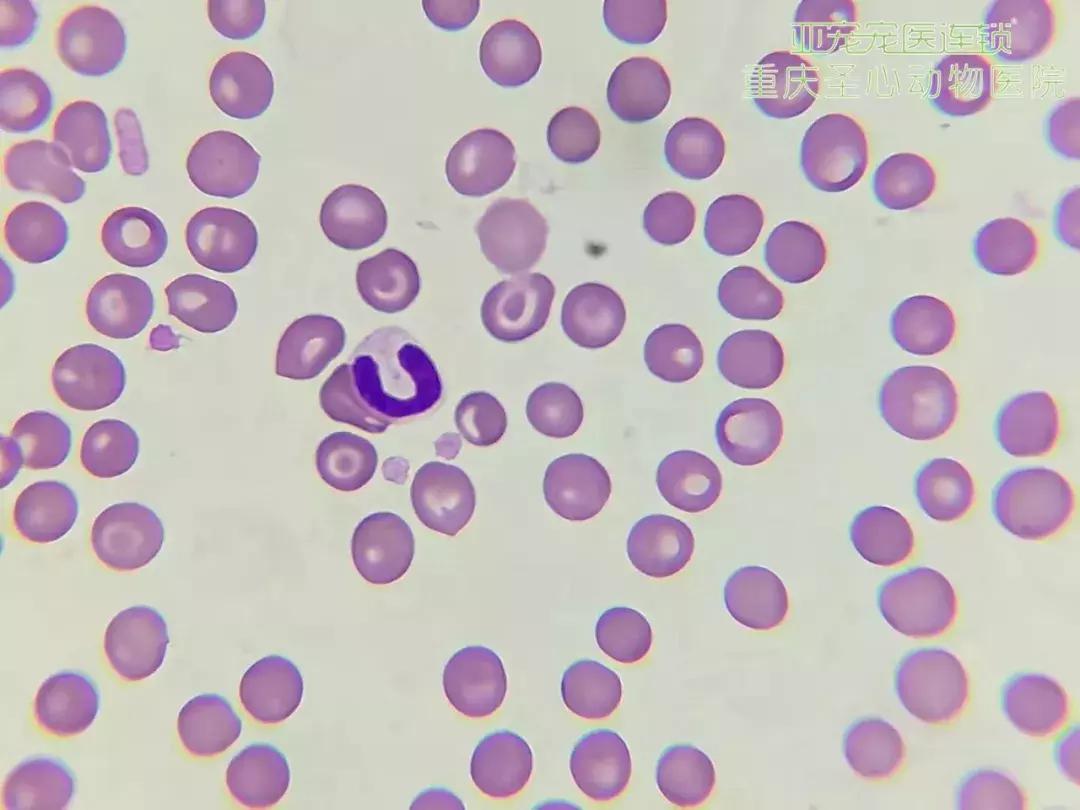
显微镜下的三千大千世界,显微镜下的世界是精美绝伦的

今天,先来看一则
由亚宠猫科分院团宠——二千
领衔主演的小故事~

二千饰演的男主角得了皮肤病
女主角显微镜检查后发现
原来是病菌在作祟
找到“反派人物”的二千十分开心
只要配合兽医爸爸的治疗
就能很快恢复健康啦!

其实不止皮肤病
还有很多疾病都可以通过采样后
使用显微镜进行鉴别诊断

小小的身体大大的作用
显微镜的主要功能就是把微小的物体放大,然后让人可以观察到被检查物体的结构以方便人们更好地研究物质组成。
显微镜结构解析图
▼▼▼

在小动物诊疗过程中
显微镜能帮助医生更好地判定
患宠的疾病类型及致病的原因

细胞学检查范围很广,可以检查皮肤、血液、尿液、体液、粪便、肝脏等。镜检也是所有检查项目中最基本的,也可以作为肿瘤的早期诊断,通过镜检医生可以对患宠的疾病做出早期的预测和治疗方向的规划。这些都是医疗人员可以在自己的实验室完成的,因此大大节约了成本和客人的时间。
显微镜判读步骤▼

显微镜最常用的四种检查:
① 皮肤检查
从宠物皮肤病患处取下皮屑观察,可检测疾病如:表皮囊肿、舔舐性皮炎、红斑、皮肤黄疸等。
② 粪检
采集粪便样本观察,可检测疾病如:体内寄生虫、结肠炎、原壁菌病、隐球菌病等。
③ 耳检
采集耳垢样本观察,可检测疾病如:外耳炎、耳螨等。
④ 尿检
采集尿液样本观察,可检测疾病如:尿结石、细菌性膀胱炎等。

接下来见证
显微镜下原形毕露的“凶手”

母犬阴道抹片 传染性性病肿瘤▼

耳检 耳螨▼

粪检 球虫▼

粪检 钩虫▼

血检 红细胞自体凝集▼

血检 杆状中性粒细胞▼
尿检 鸟粪石结晶▼

皮肤蠕形螨虫卵▼

皮肤 虱▼

胸水▼

通过以上的讲解
希望大家能对镜检有更清晰的概念
显微镜就像兽医的第三只眼
帮助他们“斩妖除魔”
让患宠早日恢复健康!

—END—